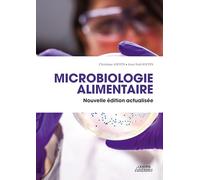
Microbiologie alimentaire

Microbiologie Alimentaire: Livre Universitaire destine auxetudiantsLicence/Master en Sciences Biologiques, Agro-Alimentaires
Microbiologie Alimentaire: Livre Universitaire destine auxetudiantsLicence/Master en Sciences Biologiques, Agro-Alimentaires

Note globale : 1,7 / 5 (moyenne issue de plusieurs sources d’avis, au 27 mai 2026)
Basé sur un total de 18 593 avis clients provenant de plateformes indépendantes.
Sources et transparence :
Les valeurs proviennent d’avis publics de marchands issus de plateformes telles que Avis Vérifiés, Custplace, Trustpilot, entre autres, et sont agrégées mensuellement.
Toutes les marques et tous les logos sont la propriété de leurs détenteurs respectifs.
Avertissement :
prix.net ne peut pas garantir que les avis publiés proviennent de consommateurs ayant réellement effectué un achat auprès du marchand évalué.
Basé sur un total de 18 593 avis clients provenant de plateformes indépendantes.
Sources et transparence :
Les valeurs proviennent d’avis publics de marchands issus de plateformes telles que Avis Vérifiés, Custplace, Trustpilot, entre autres, et sont agrégées mensuellement.
Toutes les marques et tous les logos sont la propriété de leurs détenteurs respectifs.
Avertissement :
prix.net ne peut pas garantir que les avis publiés proviennent de consommateurs ayant réellement effectué un achat auprès du marchand évalué.
Prix total le moins cher
Habituellement expédié sous 6 à 7 mois. Livraison Express possible avec Amazon Premium.
Prélèvement bancaire
Prélèvement bancaire
Visa
Visa
Mastercard
Mastercard
93,90 €
Livraison gratuite
Microbiologie Alimentaire: Livre Universitaire destine auxetudiantsLicence/Master en Sciences Biologiques, Agro-Alimentaires

Note globale : 1,7 / 5 (moyenne issue de plusieurs sources d’avis, au 27 mai 2026)
Basé sur un total de 18 391 avis clients provenant de plateformes indépendantes.
Sources et transparence :
Les valeurs proviennent d’avis publics de marchands issus de plateformes telles que Avis Vérifiés, Custplace, Trustpilot, entre autres, et sont agrégées mensuellement.
Toutes les marques et tous les logos sont la propriété de leurs détenteurs respectifs.
Avertissement :
prix.net ne peut pas garantir que les avis publiés proviennent de consommateurs ayant réellement effectué un achat auprès du marchand évalué.
Basé sur un total de 18 391 avis clients provenant de plateformes indépendantes.
Sources et transparence :
Les valeurs proviennent d’avis publics de marchands issus de plateformes telles que Avis Vérifiés, Custplace, Trustpilot, entre autres, et sont agrégées mensuellement.
Toutes les marques et tous les logos sont la propriété de leurs détenteurs respectifs.
Avertissement :
prix.net ne peut pas garantir que les avis publiés proviennent de consommateurs ayant réellement effectué un achat auprès du marchand évalué.
Prix le moins cher
Habituellement expédié sous 4 à 5 jours
Prélèvement bancaire
Prélèvement bancaire
Visa
Visa
Mastercard
Mastercard
93,90 €
Livraison à partir de 18,00 €
Microbiologie Alimentaire: Livre Universitaire destine auxetudiantsLicence/Master en Sciences Biologiques, Agro-Alimentaires

Note globale : 1,7 / 5 (moyenne issue de plusieurs sources d’avis, au 27 mai 2026)
Basé sur un total de 18 391 avis clients provenant de plateformes indépendantes.
Sources et transparence :
Les valeurs proviennent d’avis publics de marchands issus de plateformes telles que Avis Vérifiés, Custplace, Trustpilot, entre autres, et sont agrégées mensuellement.
Toutes les marques et tous les logos sont la propriété de leurs détenteurs respectifs.
Avertissement :
prix.net ne peut pas garantir que les avis publiés proviennent de consommateurs ayant réellement effectué un achat auprès du marchand évalué.
Basé sur un total de 18 391 avis clients provenant de plateformes indépendantes.
Sources et transparence :
Les valeurs proviennent d’avis publics de marchands issus de plateformes telles que Avis Vérifiés, Custplace, Trustpilot, entre autres, et sont agrégées mensuellement.
Toutes les marques et tous les logos sont la propriété de leurs détenteurs respectifs.
Avertissement :
prix.net ne peut pas garantir que les avis publiés proviennent de consommateurs ayant réellement effectué un achat auprès du marchand évalué.
Prix le moins cher
Habituellement expédié sous 4 à 5 jours
Prélèvement bancaire
Prélèvement bancaire
Visa
Visa
Mastercard
Mastercard
93,90 €
Livraison à partir de 59,99 €
🤖 Demande à ChatGPT
💡 Est-ce que ça vaut le prix ?
🔁 Y a-t-il de meilleures alternatives ?
⭐ Qu'en disent les utilisateurs ?
Microbiologie Alimentaire: Livre Universitaire destine auxetudiantsLicence/Master en Sciences Biologiques, Agro-Alimentaires - Détails
▶ Trouvez toujours le prix le plus bas !
Nous avons trouvé 3 prix pour Microbiologie Alimentaire: Livre Universitaire destine auxetudiantsLicence/Master en Sciences Biologiques, Agro-Alimentaires. Notre liste de prix est toujours transparente et affichée par ordre de prix croissant. Des frais de livraison peuvent s'ajouter.
Microbiologie Alimentaire: Livre Universitaire destine auxetudiantsLicence/Master en Sciences Biologiques, Agro-Alimentaires - Informations sur les prix
- Prix le plus bas: 93,90 €
- Le prix le plus bas est proposé par amazon-marketplace.fr. Vous pouvez commander le produit ici.
- Le prix pour le produit Microbiologie Alimentaire: Livre Universitaire destine auxetudiantsLicence/Master en Sciences Biologiques, Agro-Alimentaires varie entre 93,90 €€ à 93,90 €€ avec un total de 3 offres.
- Méthodes de paiement: le marchand en ligne amazon-marketplace.fr accepte : Prélèvement bancaire, Visa, Mastercard.
- Livraison: le délai de livraison le plus court allant de Habituellement expédié sous 4 à 5 jours jours ouvrés est proposé par amazon-marketplace.fr
Produits similaires

144,10 €
amazon-marketplace.fr
Livraison à partir de 8,90 €

Microbiologie, hygiène et droit alimentaire
45,95 €
amazon-marketplace.fr
Livraison à partir de 35,82 €

43,90 €
Amazon.fr
Livraison gratuite
84,00 €
Amazon.fr
Livraison gratuite

Manuel pratique du laboratoire de microbiologie alimentaire
43,90 €
Amazon.fr
Livraison gratuite
N'oubliez pas votre code promo :
Signaler une infraction
Vous êtes sur le point de signaler une infraction légale sur la base de la loi sur les services numériques de l'UE.